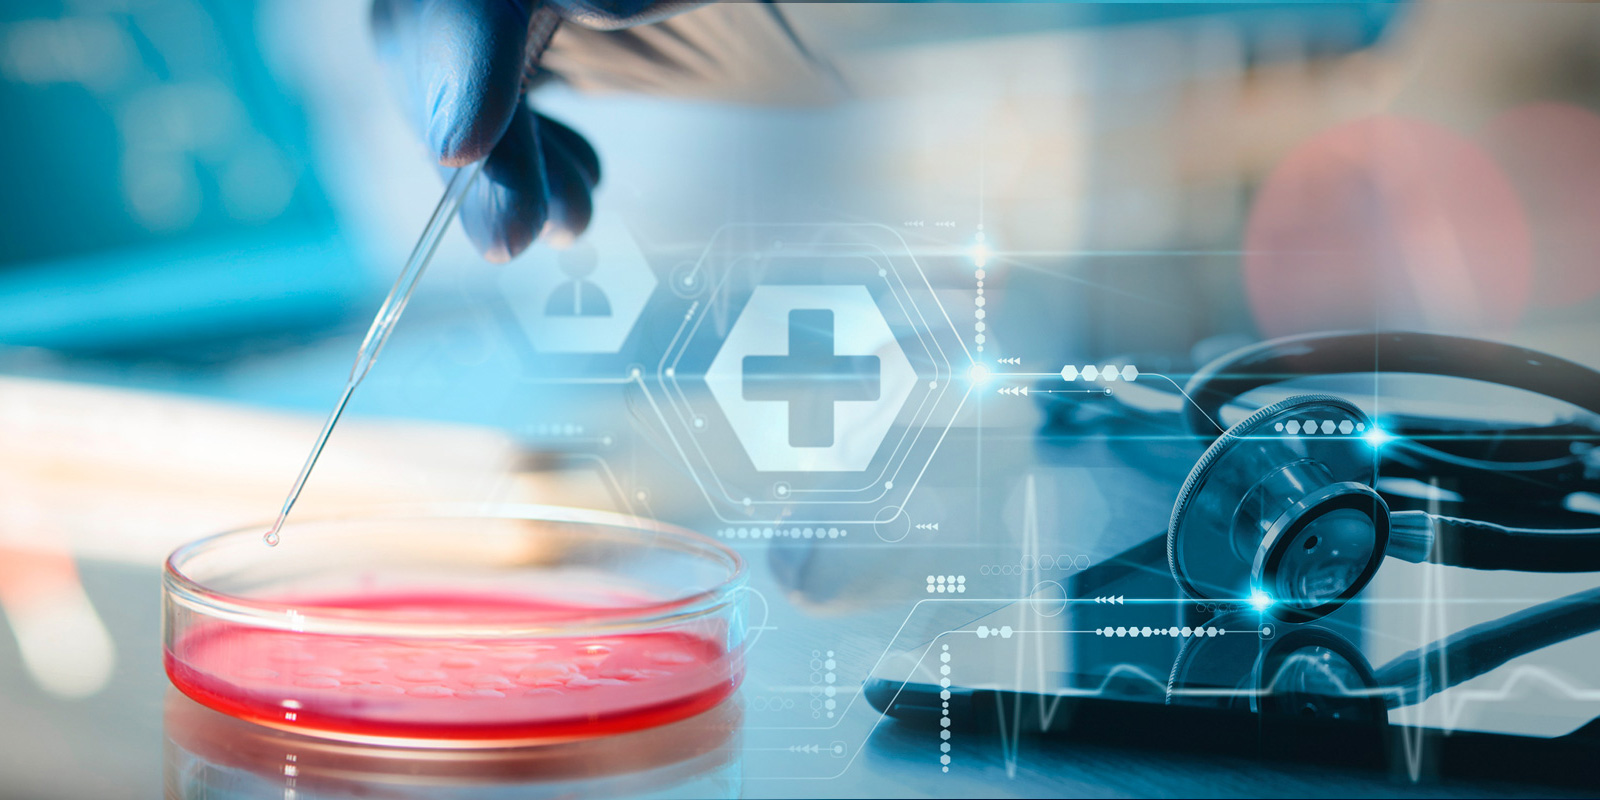
EU_Proposes_Extended_Deadlines_to_Certify_Medical

EU Commission Proposes Extended Deadlines to Comply with the Medical Device Regulation and In Vitro Diagnostic Regulation
In Short
The Situation: The transition to the new so-called Medical Device Regulation ("MDR") and In Vitro Diagnostic Regulation ("IVDR"), which establish new rules for the placing on the market of medical devices (including diagnostics) in the European Union ("EU"), and which were adopted in 2017, has been plagued with uncertainty and delays. Many manufacturers are still not ready, and this leads to the risk of shortages of many devices in the EU, given the upcoming deadlines for compliance with the new rules and the fact that noncompliant devices will be banned.
The Result: On 6 January 2023, the European Commission ("Commission") issued a Proposal for a Regulation ("Proposal") extending the period during which devices compliant with the old EU legislation on medical devices can continue to be placed on the EU market. The Commission has also proposed to eliminate any "sell-off" restrictions for devices legally placed on the market during the transition time.
Looking Ahead: The Proposal has been widely welcomed by industry representatives, while not being immune from some criticism. It must be adopted by the European Parliament and Council through an accelerated co-decision procedure before it can become law. Medical devices manufacturers selling in the EU should monitor the legislative process initiated by the Proposal, as well as guidance issued on the interpretation of its provisions.
Background
In 2017, the EU adopted two regulations, namely the MDR (Regulation No (EU) 2017/745) and the IVDR (Regulation No (EU) 2017/746) on medical devices and in vitro diagnostic medical devices, respectively. These regulations were aimed at progressively replacing the previous rules on devices in the EU, namely Directive 93/42/ECC for medical devices and Directive 90/385/ECC for active implantable medical devices, as well as Directive 98/79/EC on in vitro medical devices (collectively, the "Directives").
The MDR and IVDR introduced new and more robust conformity assessment rules for medical devices and additional requirements, for example, with regards to the designation and oversight of the so-called "Notified Bodies" (i.e., conformity assessment bodies), as well as on the clinical evidence requirements, the vigilance and market surveillance, and the traceability of medical devices.
Transition Deadlines and Sell-off Restrictions
The MDR currently provides for a transition period, ending on 26 May 2024, during which devices covered by certificates issued from 25 May 2017 under the applicable Directives would remain valid for a maximum period of five years after the date of their issuance, and not beyond 27 May 2024.
As for the IVDR, in January 2022 the Council and the European Parliament had already decided on a general extension of the transition period (as applicable to certificates) to 26 May 2025, with longer extensions to 26 May 2026, and 26 May 2027 for certain classes of devices for which the conformity assessment procedure pursuant to Directive 98/79/EC did not require the involvement of a Notified Body and for which such involvement is now required under the IVDR. A new deadline of 26 May 2028 was also introduced for the application of certain provisions concerning devices manufactured and used in health institutions.
Both the MDR and the IVDR currently contain provisions limiting the "sell-off" period of devices legally placed on the market on the basis of certificates issued under the Directives.
Compliance Delays
The transition to compliance with the MDR and IVDR has been slower than anticipated by the Commission. There are multiple reasons that the Commission cites for that. First, few Notified Bodies are authorized to issue certifications of conformity under the new rules, and they therefore have insufficient capacity to timely complete such certifications for all devices in need of certification (or re-certification). Second, many manufacturers, particularly those of small and medium size—of which there are many selling in the EU—are inadequately prepared to meet the stricter requirements dictated by these regulations. Third, the Commission cites the COVID pandemic and the war in Ukraine as having further exacerbated the situation of an already stressed European health system by affecting global supply chains, clinical investigations, and on-site audits. As a result, the continued availability of medical devices on the EU market is threatened, raising the risk of shortages affecting the needs of European patients.
Was this foreseeable? Yes.
Sure enough, the pandemic put a huge strain on the "Europe" system, just like it did on the rest of the world; and sure enough, the tragic events of the Ukraine war did not help. However, the explosive combination of more stringent rules—both on product certification and on qualification, oversight, and appointment of Notified Bodies—with the (very predictable) fewer number of accredited Notified Bodies became the perfect recipe for the totally engulfed certification scenario that Europe experienced in recent years.
Only exceptionally motivated (and resourceful) manufacturers were able to be fully prepared in time for the switchover. But that was not enough to cover all the devices that are needed in the EU—which is what ultimately has led to the proposed course correction by the Commission.
Proposal
Validity of Certificates and Transition Period Extended. The Proposal aims to extend the transition period for devices covered by a certificate or declaration of conformity issued under the old rules (the so-called "legacy devices"), subject to certain conditions.
In particular, the Commission is proposing to amend the MDR to extend the validity of certificates issued under the applicable Directives, thereby extending the transition period during which such devices can be placed on the EU market. Indeed, under the current rules, after the expiry of the certificates issued under the Directives, and absent a valid certificate issued under the new rules, the related devices cannot be placed on the EU market any longer. As mentioned, under the current MDR rules, the validity of these certificates terminates upon either the period indicated on the certificate (which cannot exceed five years from its issuance) or by 27 May 2024, whichever is shorter.
Under the Proposal, the MDR would be amended to ensure that certificates issued from 25 May 2017, which were still valid on 26 May 2021 and not withdrawn before the date of entry into force of the amendment, remain valid until:
a.) 31 December 2027, for class III devices and for class IIb implantable devices, except sutures, staples, dental fillings, dental braces, tooth crowns, screws, wedges, plates, wires, pins, clips, and connectors; and
b.) 31 December 2028, for class IIb devices other than those covered by point (a) above, for class IIa devices, and for class I devices placed on the market in sterile conditions or having a measuring function.
For certificates still valid on 26 May 2021 but expired before the entry into force of the amendment, specific conditions apply. Furthermore, the Proposal provides that devices not previously requiring the involvement of a Notified Body, but which now require such involvement under the MDR, and for which a declaration of conformity was drawn up prior to 26 May 2021, may be placed on the market or put into service until 31 December 2028.
To benefit from these extended deadlines, however, two sets of conditions apply, namely:
First, the devices:
- Must continue to comply with the applicable Directives;
- May not have been subject to significant changes in design and intended purpose;
- Cannot present an unacceptable risk to the health or safety of patients, users, or other persons or public health.
Second, the manufacturer (or authorized representative, as applicable) must have taken certain steps for compliance with the new rules, namely:
- Putting in place a quality management system in accordance with Article 10(9) of the MDR; and
- Submitting an application to a Notified Body for conformity assessment under the new rules no later than 26 May 2024, as well as signing a written agreement with a Notified Body no later than 26 September 2024.
No More Sell-off Restrictions. The Proposal also aims at removing the so-called "sell-off" deadline introduced under both the MDR and the IVDR, under which devices already in the supply chain had to reach their final user by a certain date. It is now proposed to eliminate such restriction, which means that once products are placed on the market (e.g., they are sold by the manufacturer to a distributor and sit on the distributor's shelves), no further time limitation to their selling-on (e.g., by the distributor to the end-user) will apply. Removing this limitation, according to the Commission, is aimed at avoiding unnecessary disposal of safe medical devices that are already on the market and that simply have not reached their final user. Initially, the sell-off deadline caused significant anxiety when introduced, as it was at odds with a long-standing approach adopted in most EU product legislation, according to which, once a product is legally placed on the EU market, it can stay there with no further limitation to its further making available or putting into service, unless, of course, such product is shown to cause an unacceptable risk—e.g., to human health. In the latter case, safeguard provisions aimed at removing the product from the market typically apply.
Market Response
An accelerated period of consultation of interested stakeholders was launched by the Commission on the Proposal on 11 January 2023 and ended on 18 January 2023. More than 240 submissions were received in that week and signaled, in general, wide industry support, including from MedTech Europe, the European association regrouping the medical technology industry, including diagnostics, medical devices, and digital health.
However, some have pointed to the financial and time resources that some manufacturers did invest in the past few years to be compliant in time. Some others have objected to the condition that dictates that, to remain on the market, devices must not undergo significant changes in design and intended purpose. This, it has been noted by several contributors, could stop further innovation and improvement of products now that these products can stay on the market for an extended period of time. Also, concerns about the availability of Notified Body resources continue to be flagged and are, according to some, not sufficiently addressed by the proposed extensions.
Many questions on the practical implementation of the proposed rules have also been raised. For example, it has been noted that the fact that dates on certificates will not be extended (the Proposal explains that the extension is directly applicable, so that Notified Bodies are not required to change the date on the individual certificates) could create a situation of legal uncertainty, especially with regards to non-EU players (including authorities) looking at interpreting the validity of such certificates for products exported outside of the EU. Another key concern is around the interpretation of the rule, according to which the extended transition period would cease if the concerned device "presents an unacceptable risk" to health and safety.
Two Key Takeaways
- The Proposal is an important step to ensure that medical devices manufacturers can rely on an extended period of time to ensure compliance with the new rules for their products. It does not, however, solve many interpretation questions that were already raised with regards to both IVDR and MDR, and it introduces new questions on the practical implementation of some of its provisions.
- It is of paramount importance for players active in medical devices in the EU, whether manufacturers, importers, distributors, or other economic operators, to continue to monitor closely the legislative process started by the Commission, including any changes the Proposal may undergo until its approval by the Parliament and the Council, assuming, of course, that such approval will materialize. It will also be important to monitor any guidance issued for the practical application and interpretation of the Proposal once it becomes law.